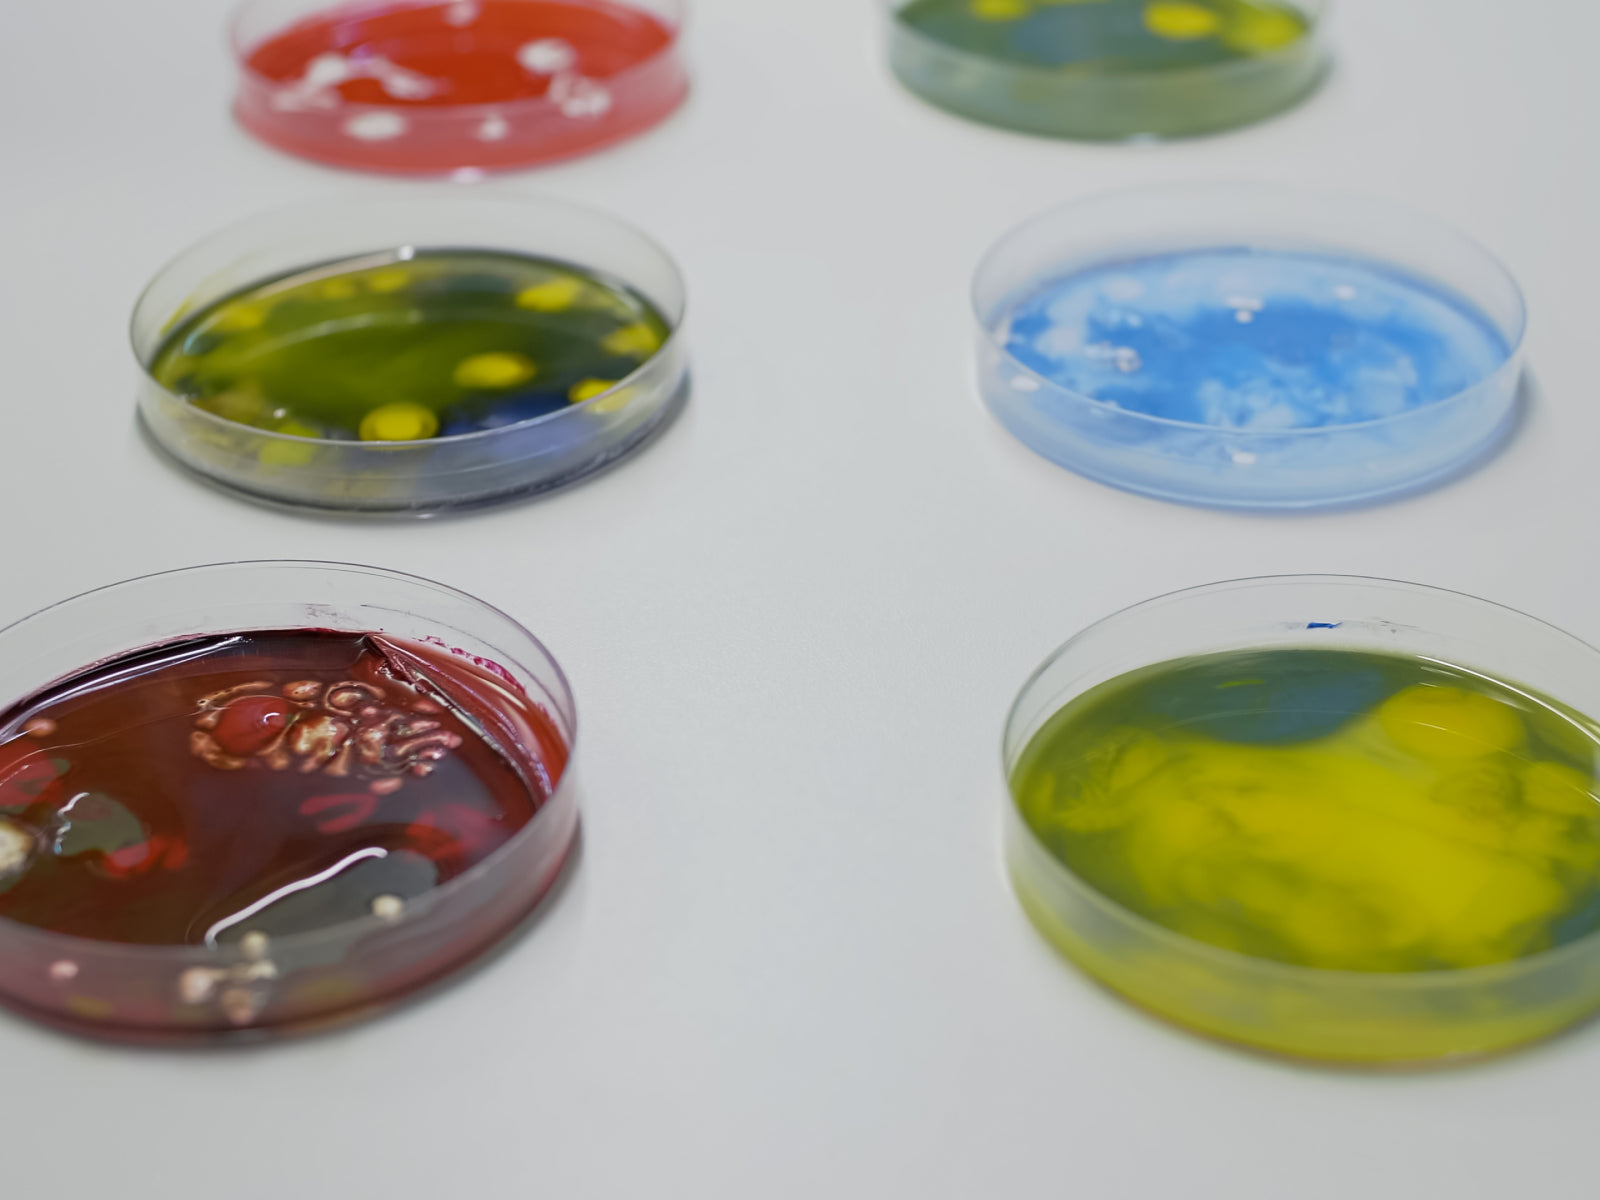

Darm-Mykobiota auf dem Prüfstand: Darmbewohner oder nur Durchreisende?
Der menschliche Darm beherbergt ein komplexes mikrobielles Ökosystem, das aus einer Vielzahl von Arten besteht, darunter Bakterien, Archaea, Viren, Protisten und Pilzen. In den letzten 15 Jahren hat die Wissenschaft große Anstrengungen unternommen, um die Rolle von Bakterien in der menschlichen Physiologie und Krankheitsentwicklung zu verstehen.
Aber es ist jetzt klar, dass Zusammenarbeit und Multi-Biom-Interaktionen die Grundlage für das Darmgleichgewicht und immunologische Reaktionen sind. Und auch andere Gemeinschaften spielen eine wichtige Rolle bei Gesundheit und Krankheit.
Werfen wir einen genaueren Blick auf die Pilzkomponente, die als „das Mykobiom“ bekannt ist, um zu sehen, warum sie für deine Darmgesundheit wichtig sind.
Pilzgemeinschaften im Darm
Pilze stellen einen untergeordneten Bestandteil des gesamten Darms dar und machen nur 0,1 % der gesamten Mikroben aus. Ja! So wenig und vielleicht kann dies erklären, warum sie trotz ihrer Bedeutung kaum verstanden werden.
Die wissenschaftlichen Bemühungen der letzten Jahre, das „gesunde“ menschliche Mikrobiom zu charakterisieren, haben jedoch einiges Licht auf die Funktion des Mykobioms geworfen.
Im Vergleich zu Bakterien weist das Mykobiom des menschlichen Darms eine geringe Diversität auf, da im Allgemeinen weniger als 20 Arten identifiziert wurden.
Studien deuten darauf hin, dass sowohl die inter- als auch die intraindividuelle Variabilität hoch ist. Das bedeutet, dass das Mykobiom eines Individuums im Gegensatz zu bakteriellen Gemeinschaften sich selbst im Laufe der Zeit nicht ähnlicher ist als dem einer anderen Person.
Trotz dieser Tatsache deuten mehrere Pilzarten, die in Proben vieler Studien identifiziert wurden, darauf hin, dass eine Kern-Darmmykobiota existieren könnte. Interessanterweise ermöglicht die hohe Prävalenz von zehn identifizierten Gattungen eine tiefere Charakterisierung des Pilzmikrobioms.
Die Liste dieser Arten wird sich weiterentwickeln, wenn sich die Analysetechniken verbessern und die Datenmenge zunimmt.
Den meisten Studien zufolge waren Hefen der Gattungen Saccharomyces, Malassezia und Candida die dominierenden Pilze, die in Stuhlproben gefunden wurden.
Saccharomyces spp. sind in der Lebensmittel- und Getränkeindustrie weit verbreitet, und lassen sich in Lebensmitteln wie Wein, Brot oder Bier finden.Malassezia spp. ist ein bekannter Bewohner der Haut.
Während es noch viele Fragen gibt, ob Saccharomyces und Malassezia wirklich als echte Darmbewohner angesehen werden sollten, gelten Arten der Gattung Candida als echte symbiotische Darmpilze.
Wechselwirkungen zwischen Pilzen und Bakterien
Kommensale Bakterien sind aus so vielen Gründen unglaublich vorteilhaft für unsere Gesundheit. Sie beeinflussen die Art und Weise, wie wir Nahrungsnährstoffe aufnehmen, helfen uns, die Besiedelung von Krankheitserregern zu bekämpfen, die Integrität der Epithelbarriere aufrechtzuerhalten und sind auch an unseren Immunantworten beteiligt.
Aber ein stabiles Gleichgewicht all unserer Mikroben scheint der Schlüssel zu sein, um die Gesundheit zu optimieren und sicherzustellen, dass all diese Funktionen ordnungsgemäß ausgeführt werden.
Wir wissen, dass zwischen bakteriellen und pilzlichen Mikroorganismen im Darm eine konkurrierende Assoziation besteht.
Fazit: Wechselwirkungen zwischen Bakterien und Pilzen sind unerlässlich, um das übermäßige Wachstum von Mikroben und die Entwicklung von Krankheiten zu verhindern.
Candida albicans, die wichtigste Pilzart im menschlichen Darm
Candida albicans ist eine Pilzart, die häufig im Stuhl gesunder Menschen vorkommt und dort in der Regel keine Probleme verursacht.
Warum wird es also immer mit schlechter Presse in Verbindung gebracht?
Bestimmte Bedingungen, wie ein unausgeglichenes Mikrobiom, eine Unterdrückung des Immunsystems und eine gestörte Darmbarriere, können zu C.albicans-Infektionen führen.
Das übermäßige Wachstum dieses gutartigen Organismus ist etwas, das wir mit Tests erkennen und zukünftigen gesundheitlichen Komplikationen vorbeugen können.
Der Pilz kann neben dem Darm auch mehrere Körperteile besiedeln. Candida-Infektionen treten typischerweise in der Vagina, im Mund und Rachen bei Personen mit geschwächtem Immunsystem auf. Obwohl sie die Lebensqualität beeinträchtigen, verschwinden sie bei richtiger Diagnose und Behandlung.
Seltener kann es sich auch vom Darm in den Blutkreislauf ausbreiten und in innere Organe eindringen und invasive, lebensbedrohliche Infektionen hervorrufen.
Pilze, Darmimmunität und entzündliche Darmerkrankungen
Es ist allgemein anerkannt, dass Pilzgemeinschaften nicht nur bei Krankheiten verändert werden, sondern auch eine Rolle bei der intestinalen Homöostase spielen und die systemische Immunität beeinflussen.
Bakterien-Pilz-Wechselwirkungen sind entscheidend, um dieses Gleichgewicht aufrechtzuerhalten und uns vor Krankheiten zu schützen.
Interessanterweise können Darmpilze die Immunantwort beeinflussen, indem sie lokale Entzündungsreaktionen reduzieren oder fördern.
Anscheinend ist C. albicans ein zentraler Modulator menschlicher T-Helfer 17 (Th17)-Antworten im gesunden Zustand und während Darmentzündungen. Dysregulierte Th17-Antworten tragen zu lokalen entzündlichen Erkrankungen wie entzündlichen Darmerkrankungen bei.
Der Darm ist ein sehr komplexes Ökosystem, in dem Störungen in einem seiner Bestandteile unsere Gesundheit stark beeinträchtigen können.
Fazit
- Die Mykobiomforschung ist ein aufstrebender Bestandteil des Darmmikrobioms, aber dieses Gebiet steckt noch in den Kinderschuhen.
- Ein Kern-Darmmykobiom kann existieren und besteht wahrscheinlich aus zehn Gattungen, die in den meisten menschlichen Gastrointestinaltrakten vorkommen.
- Die Pilzvielfalt im Darm ist im Vergleich zu Bakteriengemeinschaften gering.
- Weitere Studien sind erforderlich, um zu beantworten, ob es echte Pilz-Darmbewohner gibt oder ob Pilze nur auf der Durchreise sind.
- Darmpilze prägen Immun- und Stoffwechselreaktionen auf verschiedene Weise.
- Eine vielversprechende Zukunft: Das Verständnis normaler gegenüber dysfunktionaler Wirt-Pilz-Interaktionen wird unsere Fähigkeit verbessern, die Gesundheit und personalisierte Behandlungen zu verbessern.
Autor: Cecilia Clausen (Klinische Ernährungsberaterin)